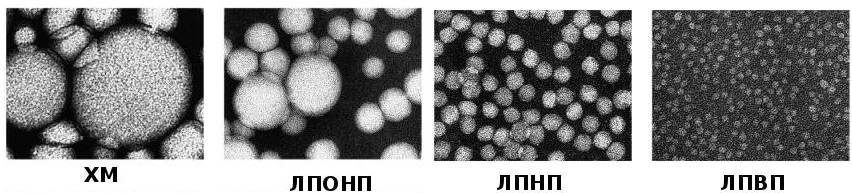

Как повысить содержание липопротеинов высокой плотности?
Чтобы повысить ЛПВП, нужно сбалансировать рацион. Если ситуация запущена и уровень ЛПВП слишком низкий, доктор назначит лекарственные препараты. Также необходима умеренная физическая нагрузка. Хорошее кровоснабжение всех частей тела способствует рассасыванию атеросклеротических бляшек и является профилактикой образования новых.
Немедикаментозное лечение
При небольшом отклонении от нормы ситуацию скорректирует диета, при тщательном соблюдении она быстро поднимет уровень ЛПВП до желаемых цифр. Ее главный принцип – исключение жиров животного происхождения и замена их растительными.

Полезные и вредные жиры.
Запрещается употреблять:
- жирное мясо;
- сало, колбасу (копченую и сырокопченую);
- мясные бульоны;
- красную и черную икру;
- жареные блюда;
- «фри» — блюда (фаст фуд);
- маргарин, сливочное масло;
- молочные продукты с высоким содержанием жира.
Растительные жиры содержатся в:
- маслах: оливковом, льняном, ореховом, кунжутном, конопляном, кукурузном;
- орехах;
- авокадо.
Замените майонез и другие соусы растительными маслами. Они не уступают по вкусу и оказывают положительное влияние на организм.
Большое значение при лечении атеросклероза имеют полиненасыщенные жирные кислоты: омега – 3, омега – 6, омега – 9. Они рассасывают холестериновые бляшки, содержатся в растительных маслах и жире рыб: форели, семги, скумбрии, сельди, мойвы. Употребляйте рыбные бульоны, они хорошо всасываются, а незаменимые жирные кислоты мгновенно усваиваются организмом.
Применение препаратов
При серьезных отклонениях ЛПВП от нормы врач назначает лекарственные средства. Препараты группы статинов отличаются высокой эффективностью и хорошей переносимостью. К этим медикаментам относятся:
- «Розарт»;
- «Розукард»;
- «Розувастатин»;
- «Аторвастатин»;
- «Аторис».
Начинают прием с дозы 5 мг один раз в сутки в вечернее время. Параллельно проводится контроль показателя ЛПВП в крови. Если ситуация не меняется, дозу повышают до 10 или 20 мг.
Функции фракций липопротеидов
Липиды выполняют важные действия в организме человека:
- Молекулы холестерина находятся во всех мембранных оболочках клеток человеческого организма;
- При помощи липидов мембраны получают свою упругость и эластичность;
- Липиды помогают в продуцировании жёлчных кислот;
- Липиды синтезируют витамин Е, А и витамин Д;
- Липиды повышают иммунитет и задерживают проникновение в мембрану вредных токсинов;
- Липиды учувствуют в выработке половых гормонов клетками надпочечников;
- Производит защиту нервных волокон от внешней среды при помощи плотной и эластичной оболочки;
- Липиды находятся в спинномозговой жидкости и соединяют между собой головной мозг и клетки спинного мозга.

Липопротеиды — это главные транспортировщики липидов по организму.
Сами по себе липиды нерастворимы в жидкости, поэтому для выполнения своих функциональных обязанностей, им необходимо связаться с белковыми соединениями.
Основным белковым соединением для липидов, является апопротеин. Липиды с апопроинами образуют липопротеины различной молекулярной плотности. Плотность молекулы зависит от количества в ней апопротеинового белка.
Все липопротеиды транспортируют молекулы жиров по организму и выполняют свои функции и отличаются по плотности и своему размеру:
| Наименование липопротеида | Размер холестериновой молекулы | Состав молекулы липопротеида | Характеристика молекул липопротеидов |
|---|---|---|---|
| Молекулы хиломикронов (ХМ) | 0,5 нм — 1,2 нм | В составе: | · формирование происходит в тонком отделе кишечника, путем всасывания стенками кишечника из продуктов питания, которые попадают в организм; |
| · триглицериды экзогенного типа (85,0%); | · хиломикроны, попадая в состав крови, достаточно быстро связываются с белковыми соединениями; | ||
| · молекулы холестерола; | · функция молекул хиломикронов — это транспортировка молекул холестерола из кишечника в клетки печени; | ||
| · холестериновый эфир. | · в составе капиллярной и венозной крови хиломикроны не диагностируются в анализе крови методом биохимии. | ||
| Липопротеиды очень низкой плотности (ЛПОНП) | От 30,0 нм до 80,0 нм | В составе: | Функциональность молекул ЛПОНП: |
| · триглицериды эндогенного типа; | · это транспортировщики холестерина, который синтезируется в клетках печени, а также в других тканях организма; | ||
| · молекулы фосфолипидов; | · триглицериды в молекуле ЛПОНП, это энергетический источник для организма; | ||
| · эфир холестерина. | · триглицериды могут проявлять свойства оседать на эндотелии артерий. Вместе с липидами, триглицериды формируют холестериновую бляшку. | ||
| Низкоплотные липопротеиды (ЛПНП) | От 18,0 нм до 26,0 нм | В составе: | · формирование молекулы ЛПНП происходит путем липолиза, когда от молекулы ЛПОНП отсоединяются триглицериды; |
| · молекулы холестерола; | · свойства ЛПНП — это транспортировка эндогенного типа холестерола в периферические органы. | ||
| · липидный эфир; | |||
| · молекулы фосфолипидов; | |||
| · в минимальном составе апопротеин. | |||
| Высокоплотные молекулы липопротеидов, которые называются хорошим холестерином (ЛПВП) | От 8,0 нм до 11,0 нм | В составе: | Особенности молекулы ЛПВП: |
| · аполипопротеины А1; | · главный собиратель свободного холестерола в системе кровотока и транспортировщик этих молекул в клетки печени, для утилизации их при помощи жёлчи; | ||
| · аполипопротеины А2; | · очищает русло кровотока от холестериновых отложений молекул ЛПНП и ЛПОНП. | ||
| · молекулы фосфолипидов. |
Липопротеиды высокой плотности – что это и какие нормы показателя
Холестерин, который свободно циркулирует в периферическом кровотоке, условно подразделяется на две фракции – «хороший» (ЛПВП) холестерин и «плохой» – ЛПНП. Такое разделение связано с особенностью функций и свойств каждого вида.

ЛПНП (холестерин низкой плотности) играет определяющую роль в формировании атероматозных поражений сосудов. Молекулам этой фракции свойственно слипаться и образовывать конгломераты между волокнами эндотелия. Так начинается процесс склерозирования сосудистой стенки, иными словами – развивается атеросклероз. Это грозное заболевание, годами подтачивающее здоровье сердечно-сосудистой системы и вызывающее инфаркты, инсульты, ишемические атаки, аневризмы.
ЛПВП – это «хороший» холестерин в крови. Таким названием он обязан свойствам. Белковые молекулы, входящие в состав ЛПВП, направлены на удаление избыточного холестерина из тканей органов и сосудистых стенок. Как правило, нормальные значения ЛПВП относительно невысоки – их концентрация в крови должна входить в диапазон от 0,7 до 1,94 ммоль/л, как у мужчин, так и у женщин.
Подробнее, нормы полезного холестерина указаны по возрасту в таблице ниже.

Уровень ЛПВП выше нормы – что это значит. Считается, если в липидограмме диагностированы повышенные ЛПВП, то риски со стороны кровеносной системы заметно снижаются. Однако верхняя граница нормы установлена не просто так. Хоть повышение ЛПВП само по себе не несет никакой опасности, оно может косвенно указывать на ряд неблагоприятных процессов в организме.
Повышение хорошего холестерина встречается редко. Исключением является период беременности, когда все параметры биохимического анализа крови могут быть выше референсных и считаются физиологической повышенной нормой. Плацента имеет холестериновую структуру, поэтому для ее формирования необходимо больше белков-переносчиков с липидами. Кроме того, повышенная продукция гормонов, субстратом которых также являются жиры, приводит к увеличению их потребности.
В большинстве клинических ситуациях, если холестерол ЛПВП повышен, это значит что риск появления атеросклероза или других сосудистых заболеваний очень низкий. Параллельно с этим, повышенные липопротеиды могут иметь и следующие негативные причины:
Алкогольная интоксикация. Из-за прямого токсического воздействия на печень, нарушаются ее детоксикационные функции. Повышенные ЛПВП является одним из маркеров этого процесса.
Биллиарный цирроз печени.
Печеночные патологии – жировой гепатоз, при котором равномерно завышенные процессы синтез липопротеидов всех фракций.
Генетически детерминированная гиперхолестеринемия
При этом заболевании, повышенный биосинтез и других фракций липидов, поэтому для установки диагноза, необходимо обратить внимание не только на ЛПВП, но и на все остальные повышенные показатели липидного профиля.
Дисфункция щитовидной железы – гипотиреоз.
Неправильное питание – поступление излишнего количества продуктов которые содержат животные жиры.
Гиподинамия и неправильный, малоактивный образ жизни. Холестериновые молекулы – это маленькие энергетические станции в крови
Они транспортируются в мышцы и другие энергозатратные органы. Когда человек ведет сидячий малоподвижный стиль жизни, холестерин не востребован в тех объемах, в которых он присутствует в кровотоке. Из-за ненадобности, этот избыток может трансформироваться в низкоплотную фракцию и начать оседать на эндотелии сосудов.
Табакокурение.
Согласно медицинской статистике, повышение ЛПВП чаще всего говорит о неправильном питании и поступлении в организм избыточного количество жиров с пищей. Зачастую в продуктах содержатся субстраты для холестерина как низкой, так и высокой плотности. Поэтому при такой этиологии, вслед за ЛПВП может быть затронуты «вредный» холестерин и триглицериды в крови.
Нормы
Какие нормы холестерина существуют? У каждой разновидности органического соединения есть собственные показатели нормы. Специалисты пользуются таким диагностическим параметром, как коэффициент атерогенности, который равен отношению всех холестеролов, ЛПОНП (липопротеинов очень низкой плотности), кроме отношения ЛПВП непосредственно к ЛПВП.
Коэффициент атерогенности должен находиться в пределах показателя 2,6–2,9. В случае когда показатель достигает 4, это свидетельствует о скоплении плохого холестерола на сосудистых стенках, что негативно отражается на здоровье человека.
Показатель нормы общего холестерина зависит от возрастной категории пациента и его пола. Усреднённым значением нормального показателя общего холестерина считается показатель 5 ммоль/л. ЛПНП при этом не должны превышать 4 ммоль/л.
Если во время диагностики отмечается повышение холестерола и риска возникновения патологий сердца и сосудов, следует использовать иные диагностические параметры, а именно:
- показатель гормона щитовидной железы;
- уровень гемоглобина;
- протромбиновый индекс.
Согласно данным статистики, почти 60% людей, возраст которых превышает 50 лет, страдают от повышенного содержания ЛПНП и пониженного процента липопротеинов высокой плотности. Стоит учитывать, что с возрастом уровень холестерола в организме повышается.
Несмотря на то что у женского пола более высокая норма органического соединения в крови, чем у мужчин, женщины менее подвержены отложению плохого холестерина на сосудистых стенках. Подобное явление происходит, благодаря защитному воздействию женских половых гормонов.
Кроме этого, в период вынашивания малыша у женщины наблюдается резкое повышение холестерина, что является абсолютно нормальным процессом, который связан с перестройкой гормонального фона. Значит, по этому поводу точно не стоит волноваться.
Немаловажно помнить, что ряд заболеваний способен вызывать повышение показателя органического соединения в крови. Например, в случаях, когда щитовидная железа не может выработать достаточное количество гормонов, ответственных за процесс регулирования концентрации холестерола, но его норма в крови значительно повышается
Показатели нормы холестерола в крови
Получая результаты теста на холестерин, важно учитывать значимость сезонного фактора, который вызывает колебания показателя органического соединения в зимний период. Незначительное отклонение от нормы наблюдается у женщин во время менструального цикла
ЛПНП по Фридвальду
Чтобы определить холестерол низкой плотности, вызывающий ряд заболеваний сердечно-сосудистой системы, Фридвальд предложил воспользоваться специально разработанной линейной формулой: ЛПНП (ldl)= показатель общего холестерола – (ЛПВП (hdl) + ТГ/5).
Также Фридвальд обратил внимание на то, что показатель триглицеридов в крови должен быть меньше 400 мг/дл. В случаях, когда измерение значений проводится в ммоль/л, стоит применять для расчётов формулу, в которой разница показателей должна быть поделена не на 5, а на 2,2
Если уровень триглицеридов превышает допустимый показатель, то специалисты рекомендуют воспользоваться иными формулами для расчётов степени концентрации ЛПНП. При сильном повышении уровня липопротеидов низкой плотности можно говорить о повышении риска развития таких заболеваний:
- инфаркта;
- инсульта;
- энцефалопатии.
Это означает, что пациенту требуется незамедлительное лечение. Значение ЛВП и ЛНП следует немедленно нормализовать.
Виды
В настоящее время выделяют следующие виды липопротеинов:
ЛПВП (липопротеины высокой плотности)

ЛПВП обеспечивают транспорт холестерина от тканей организма к печени.
ЛПВП содержат фосфолипиды, которые поддерживают холестерин во взвешенном состоянии и предупреждают его выход из кровяного русла. ЛПВП синтезируются в печени и обеспечивают обратный транспорт холестерина из окружающих тканей к печени на утилизацию.
- Увеличение ЛПВП в крови отмечают при ожирении, жировом гепатозе и билиарном циррозе печени, алкогольной интоксикации.
- Снижение ЛПВП происходит при наследственной болезни Танжера, обусловленной скоплением холестерина в тканях. В большинстве прочих случаев снижение концентрации ЛПВП в крови — признак атеросклеротического повреждения сосудов.
ЛПНП (липопротеины низкой плотности)
ЛПНП являются переносчиками эндогенного холестерина, триглицеридов и фосфолипидов от печени к тканям.
Данный класс ЛП содержит до 45% холестерина и является его транспортной формой в крови. ЛПНП образуются в крови в результате действия на ЛПОНП фермента липопротеинлипазы. При его избытке на стенках сосудов появляются атеросклеротические бляшки.
В норме количество ЛПНП составляет 1,3-3,5 ммоль/л.
- Уровень ЛПНП в крови повышается при гиперлипидемии, гипофункции щитовидной железы, нефротическом синдроме.
- Пониженный уровень ЛПНП наблюдается при воспалении поджелудочной железы, печеночно-почечной патологии, острых инфекционных процессах, беременности.

инфографика (увеличение по клику) – холестерин и ЛП, роль в организме и нормы
ЛПОНП (липопротеины очень низкой плотности)
ЛПОНП образуются в печени. Они переносят эндогенные липиды, синтезируемый в печени из углеводов, в ткани.
Это самые крупные ЛП, уступающие по размерам лишь хиломикронам. Они более, чем на половину состоят из триглицеридов и содержат небольшое количество холестерина. При избытке ЛПОНП кровь становится мутной и приобретает молочный оттенок.
ЛПОНП — источник «плохого» холестерина, из которого на эндотелии сосудов образуются бляшки. Постепенно бляшки увеличиваются, присоединяется тромбоз с риском острой ишемии. ЛПОНП повышены у больных с сахарным диабетом и болезнями почек.
Хиломикроны
Хиломикроны отсутствуют в крови у здорового человека и появляются только при нарушении обмена липидов. Хиломикроны синтезируются в эпителиальных клетках слизистой оболочки тонкого кишечника. Они доставляют экзогенный жир из кишечника в периферические ткани и печень. Большую часть транспортируемых жиров составляют триглицериды, а также фосфолипиды и холестерин. В печени под воздействием ферментов триглицериды распадаются, и образуются жирные кислоты, часть которых транспортируется в мышцы и жировую ткань, а другая часть связывается с альбуминами крови.
как выглядят основные липопротеины
Представители всех остальных классов ЛП доставляют холестерин в клетки. Холестерин – это липопротеид, входящий в состав клеточной стенки. Он участвует в образовании половых гормонов, процессе желчеобразования, синтезе витамина Д, необходимого для усвоения кальция. Эндогенный холестерин синтезируется в печеночной ткани, клетках надпочечников, стенках кишечника и даже в коже. Экзогенный холестерин поступает в организм вместе с продуктами животного происхождения.
Когда назначают анализ крови на холестерин?
Биохимический анализ состава крови на холестерол с липидным профилем, в котором указаны показатели молекул ЛНВП, ЛПНП и ТГ назначают при таких патологиях:
- В целях профилактики после 20-ти лет у пациентов с генетической гиперхолестеринемией;
- Если повышенный общий индекс холестерола в составе плазмы крови;
- У пациентов, в которых в анамнезе предрасположенность к патологиям сердечного органа и системе кровотока;
- Артериальная гипертензия с сильно высокими показателями АД;
- При патологиях и сбое в эндокринной системе — патология сахарный диабет первого и второго типа;
- Абдоминального типа ожирение — в женском организме — талия больше, чем 80 сантиметров, у мужчин — больше 94 сантиметров;
- В случае нарушения обмена липидов;
- Постинсультный и послеинфарктный период;
- При ишемии сердечного органа;
- При соблюдении диеты или в период медикаментозного курса снижения фракций холестерина в составе плазмы крови.
Как подготовиться?
Что провести правильный анализ биохимии на холестерол, необходимо перед процедурой, пациенту выполнять рекомендации в подготовке организма:
- Кровь на биохимию берется только венозная и процедура должна проходить в утренние часы – не позднее 10 часов;
- Не кушать перед сдачей состава крови 10 часов, а также запрещается, не есть более 12 часов, потому что организм начинает ослабевать и у него начинает истощаться энергетический запас, и происходит забор энергии с запасов триглицеридов. Этот процесс приводит к искажению результатов всех показателей в липограмме;
- За одни — двое суток до процедуры сдачи крови на анализ не принимать алкоголь;
- За пару часов до времени назначения процедуры — не курить;
- Утром можно выпить не более 150 — 200 миллилитров очищенной воды;
- Если пациент принимает лекарственные средства, тогда необходимо об этом проинформировать доктора. Прием лекарств может искажать липограмму и показывать пониженный индекс ЛПВП;
- За неделю до процедуры забора крови, необходимо прекратить прием таких медикаментозных средств: витаминов, антибактериальных и гормональных препаратов, а также диуретических средств. Медикаменты влияют на состав крови и могут показать, что молекулы ЛПВП повышены или понижены. При такой липограмме доктор не сможет точно выявить результаты липограммы;
- У женщин нет ограничения по сдаче крови на липидный профиль, кровь можно сдавать и в период менструации.

Анализ крови на холестерин
Нормы липопротеидов высокой плотности
| пол пациента | возрастная категория | норма ЛПВП ммоль/литр | оптимальная концентрация ЛПВП в мг/дл | средний индекс ЛПВП в мг/дл | опасный показатель ЛПВП в мг/дл |
|---|---|---|---|---|---|
| мужчины | 0 – 14 лет | 0,780 — 1,680 | 55,0 — 45,0 | 40,0 — 54,0 | меньше 40,0 |
| с 15-ти – 20-ти | 0,780 — 1,680 | 55,0 — 45,0 | 40,0 — 54,0 | меньше 40,0 | |
| с 20-ти до 29-ти | 0,780 — 1,810 | 60,0 0 70,0 | 45,0 — 59,0 | меньше 45,0 | |
| с 30-ти – 39-ти | 0,780 — 1,810 | 60,0 0 70,0 | 45,0 — 59,0 | меньше 45,0 | |
| с 40-летия и старше | 0,780 — 1,810 | 60,0 0 70,0 | 45,0 — 59,0 | меньше 45,0 | |
| женщины | 0 – 14 лет | 0,780 — 1,68 | 55,0 — 65,0 | 50,0 — 54,0 | меньше, чем 50 |
| с 15-ти – 20-ти | 0,780 — 1,810 | 55,0 — 70,0 | 50,0 — 54 | меньше, чем 50 | |
| с 20-ти до 29-ти | 0,780 — 1,940 | 60,0 — 75,0 | 50,0 — 59,0 | меньше, чем 50 | |
| с 30-ти – 39-ти | 0,780 — 2,070 | 60,0 — 80,0 | 50,0 — 59,0 | меньше, чем 50 | |
| с 40-летия и старше | 0,780 — 2,20 | 60,0 — 85,0 | 50,0 — 59,0 | меньше, чем 50 |
По результатам показаний центра научных исследований NICE, понижение индекса липопротеидов высокой молекулярной плотности всего на 5,0 миллиграмм/децилитр увеличивает развитие патологий системы кровотока и сердечного органа — на 30,0%, а инфаркта миокарда и мозгового инсульта — более, чем на 25,0%.
| риск развития системного атеросклероза | % молекул ЛПВП к общему холестеролу | |
|---|---|---|
| мужской пол | женский пол | |
| низкий риск развития системного атеросклероза | больше, чем 37,0 | больше, чем 40,0 |
| средний вариант развития патологии | 25,0 — 36,0 | 27,0 — 39,0 |
| уровень выше среднего | 15,00 — 24,0 | 18,0 — 26,0 |
| высокий риск развития системной патологии | 7,0 — 14,0 | 12,0 — 17,0 |
| критически высокий риск системного атеросклероза | меньше, чем 60,0 | меньше, чем 11,0 |

Хиломикроны
Что такое ЛПНП в биохимическом анализе крови?
Липопротеидами низкой плотности называют фракции «плохого» холестерина, обладающих высоким уровнем атерогенности и приводящих к развитию атеросклеротического поражения сосудистых стенок. На ранних стадиях липидного дисбаланса, когда липопротеиды низкой плотности только начинают накапливаться в сосудистой интиме, ЛПВП «захватывают» и транспортируют в печень, где происходит их превращение в желчные кислоты.
Таким образом, в организме поддерживается естественный баланс липидов. Однако, при длительном увеличении уровня ЛПНП и снижении количества ЛПВП, липопротеины низкой плотности не только накапливаются в стенке сосуда, но и провоцируют развитие воспалительной реакции, сопровождающейся разрушением эластиновых волокон, с последующим замещением их ригидной соединительной тканью.
Чем опасен высокий уровень ЛПНП?
Прогрессирование атеросклероза сопровождается значительным снижением эластичности сосудистой стенки, нарушением способности сосуда растягиваться током крови, а также сужение просвета сосуда за счет увеличения в размерах атеросклеротической бляшки (скопления ЛПНП, ЛПОНП, триглицеридов и т.д.). Все это приводит к нарушению кровотока, усилению образования микротромбов и нарушению микроциркуляции.
В зависимости о расположения очага атеросклеротического поражения сосудов, развиваются симптомы:
- ИБС (атеросклероз коронарных сосудов);
- ИНК (ишемия нижних конечностей из-за атеросклеротического поражения сосудов ног и брюшной аорты);
- ишемии головного мозга (сужение просвета сосудов шеи и мозга) и т.д.
В каких случаях назначают диагностику ЛПНП?
Уровень ЛПНП и риск развития заболеваний сердца и сосудов имеет прямую взаимосвязь. Чем выше в крови уровень липопротеидов низкой плотности, тем выше вероятность развития у пациента тяжелых патологий сердечно-сосудистой системы.
Проведение регулярного анализа крови на ЛПНП позволяет вовремя обнаружить нарушения липидного баланса и подобрать пациенту гиполипидемическую диету и, при необходимости, схему медикаментозной коррекции уровня холестерина.
Данный анализ рекомендовано раз в год проходить всем людям старше 35-ти лет. При наличии факторов риска по развитию сердечно-сосудистых заболеваний, профилактическое обследование может проводиться чаще. Также анализ показан при наличии у пациента:
- ожирения;
- сахарного диабета;
- заболеваний печени;
- патологий щитовидной железы;
- хронического панкреатита и холецистита;
- жалоб на одышку, постоянную мышечную слабость, быструю утомляемость, головокружение, снижение памяти;
- жалоб на боли в ногах, усиливающиеся при ходьбе, перемещающуюся хромоту, постоянную зябкость стоп и кистей, бледность или покраснение голеней и т.д.
Липопротеины низкой плотности в анализе крови также оценивают при беременности. Следует отметить, что умеренное повышение уровня холестерина во время вынашивания ребенка является нормальным и не требует лечения. Однако при значительном увеличении уровня липопротеинов низкой плотности увеличивается риск самопроизвольного аборта, нарушения фето-плацентарного кровотока, замирания беременности, задержки внутриутробного развития плода, преждевременных родов и т.д.
Пониженные уровни холестерина ЛПНП и ЛПВП во время беременности также может свидетельствовать о высоких рисках развития поздних токсикозов, а также кровотечения в родах.





































